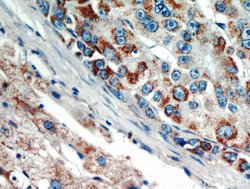
AKT2 Rabbit anti-Human, Mouse, Rat, Polyclonal, Proteintech:Antibodies:Primary

missing translation for 'onlineSavingsMsg'
Learn More
Learn More
AKT2 Rabbit anti-Human, Mouse, Rat, Polyclonal, Proteintech
Rabbit Polyclonal Antibody
132.87€ - 359.47€
Specifications
| Antigen | AKT2 |
|---|---|
| Concentration | 0.13 mg/mL |
| Applications | Immunoprecipitation, Immunohistochemistry (Paraffin) |
| Classification | Polyclonal |
| Conjugate | Unconjugated |
Description
Akt, protein kinase B (PKB), is a serine/threonine kinase, which is involved in many cellular signaling pathways and acts as a transducer of many functions initiated by growth factor receptors that activate phosphatidylinositol 3-kinase (PI 3-kinase). Akt2 is amplified and overexpressed in some human cancers.Specifications
| AKT2 | |
| Immunoprecipitation, Immunohistochemistry (Paraffin) | |
| Unconjugated | |
| Rabbit | |
| Mouse, Rat, Human | |
| P31751, P47197, Q60823 | |
| 11652, 208, 25233 | |
| AKT2 Fusion Protein Ag11770 | |
| Primary | |
| -20°C | |
| AKT2 |
| 0.13 mg/mL | |
| Polyclonal | |
| Liquid | |
| RUO | |
| PBS with 50% glycerol and 0.02% sodium azide; pH 7.3 | |
| AKT2, PKB beta, PKBB, PKBBETA, PRKBB, Protein kinase Akt 2, Protein kinase B beta, RAC BETA, RAC PK beta | |
| Akt2 | |
| IgG | |
| Antigen Affinity Chromatography | |
| Antibody |
Spot an opportunity for improvement?Share a Content Correction
Product Content Correction
Your input is important to us. Please complete this form to provide feedback related to the content on this product.
Product Title